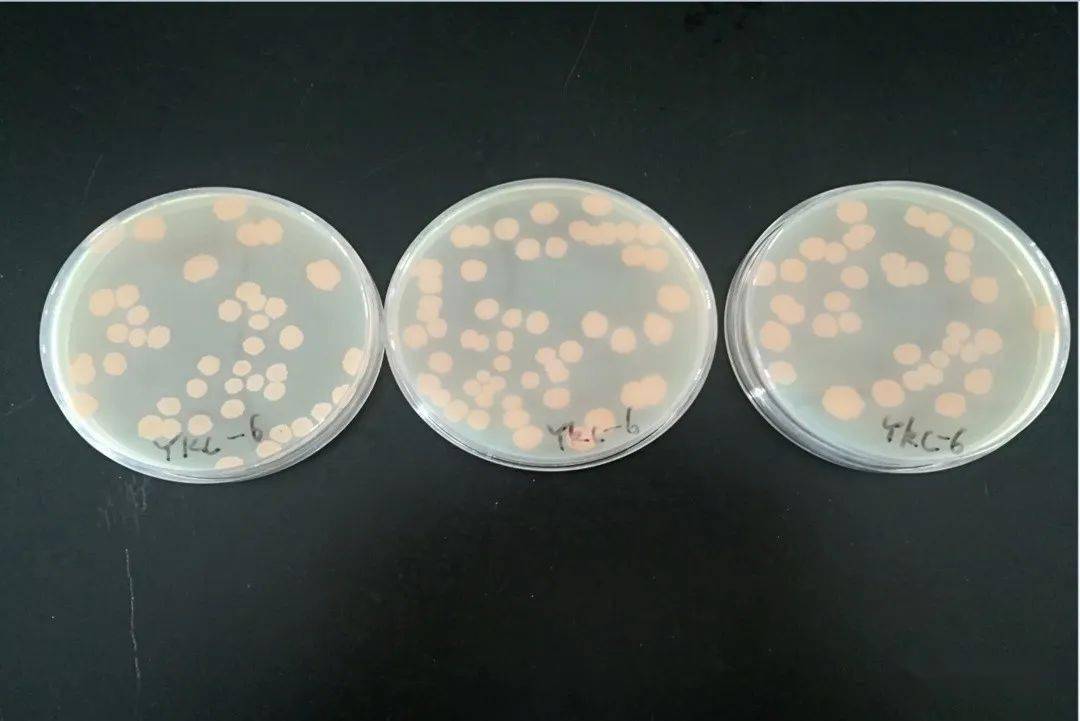
海藻糖代谢,海藻糖对植物抗逆性的作用
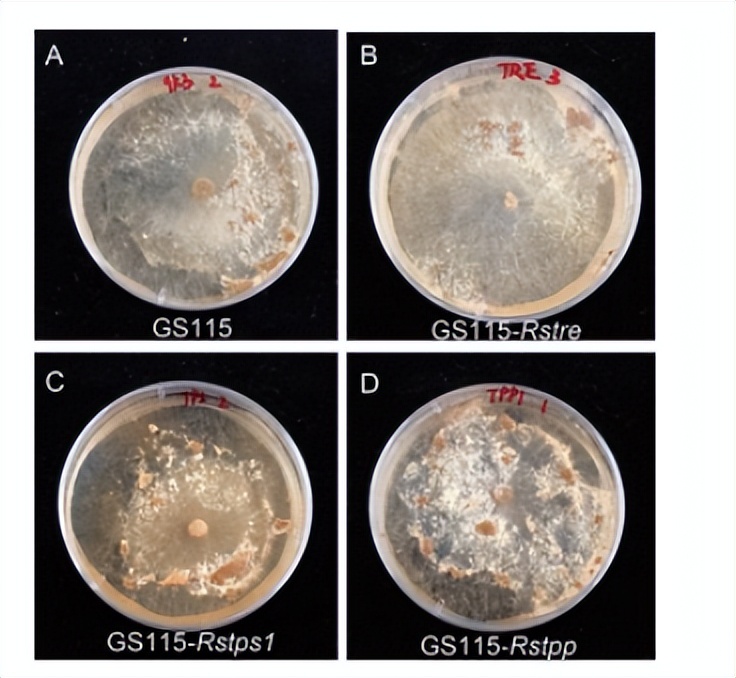
海藻糖代谢,海藻糖对植物抗逆性的作用
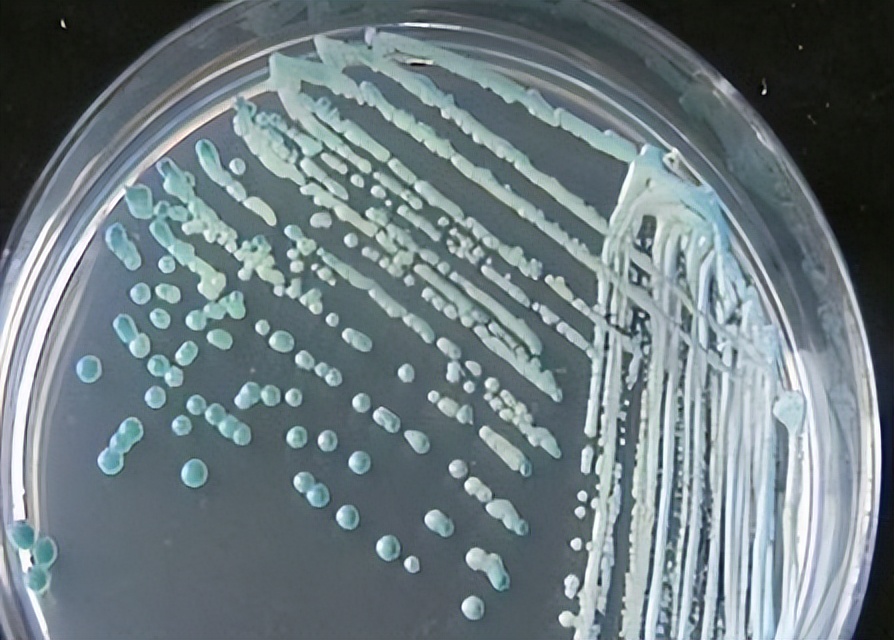
海藻糖代谢,海藻糖对植物抗逆性的作用
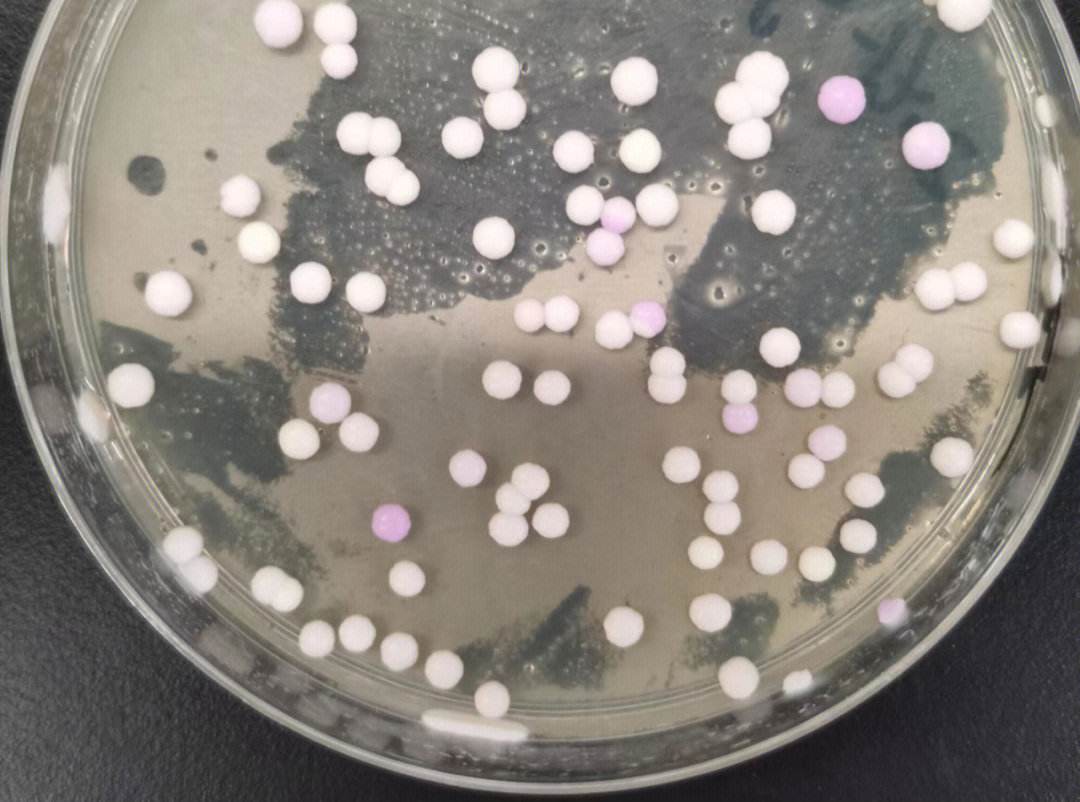
海藻糖代谢,海藻糖对植物抗逆性的作用

文|农农
编辑|农农
海藻糖酶是一种催化海藻糖水解的酶,它可以特异性和直接地将海藻糖分解成两个葡萄糖分子和海藻糖6-磷酸磷酸酶是催化海藻糖生物合成的两种酶。

在真菌中,TRE通过分解海藻糖降低真菌细胞中海藻糖的含量,而TPS1和TPP两种酶则通过诱导海藻糖的合成来增加海藻糖的含量。
因此,通过对编码这三种酶的基因tre、tps1和tpp的功能分析,可以为开发对真菌高效、对环境低风险的新型杀菌剂提供分子靶点。

在我们之前的研究中发现,海藻糖的减少会削弱活性氧的清除能力,从而导致活性氧在真菌细胞中积累,过量的活性氧会诱导番茄红霉菌的硬化发育。

实验过程与方法
1、菌株和质粒
真菌菌株GD-118是一株典型的RSB病原菌,选用毒力较强的。用大肠杆菌JM109扩增质粒DNA。

菌株和载体购自公司,带质粒的大肠杆菌JM109细胞在添加100μg/mL氨苄西林的培养基中有氧培养。
根据毕赤酵母表达试剂盒手册和毕赤酵母发酵工艺指南进行重组淀粉酶表达的培养基和培养条件。

2、总RNA的分离和cDNA的合成
为了进一步研究菌核发育过程中的基因表达谱,我们在菌核发育过程中的7个不同时间点采集了GD-118菌丝。

总RNA提取采用RNA提取试剂盒,用无水处理,根据制造商的说明,使用寡核苷酸DT和II逆转录酶合成第一链。
3、西方墨点法
将不同样品的IA的可溶性部分、细胞壁富集部分和膜富集部分蛋白在聚丙烯酰胺凝胶上运行,然后转移到尼龙膜上检测,以确定等上载量。

为了提高样品的质量,使用了一种清洁试剂盒,可以减少条纹、背景染色和其他伪影。
分别用抗体和抗体检测,与碱性磷酸盐抗兔免疫球蛋白G反应后,与5-溴-氯-3-吲哚-磷酸硝基蓝四氮唑反应。

电泳和Western blot实验采用可溶性部分、细胞壁富集部分和膜富集部分等量蛋白。
然而,由于RSTRE抗体制备失败,我们没有进行RSTRE的Western blot。

4、RSTRE、RSTPS1和RSTPP酶活性测定
为测定酶活性,将0.3 g菌丝样品匀浆于5.0 mL含有1 mmol/L 和1%聚乙烯吡罗烷酮的50 mmol/L磷酸钾缓冲液(pH 7.0)中。
匀浆在4℃下以15000 r/min离心20 min,立即用上清进行酶活性测定,以牛血清白蛋白为标准,测定蛋白质含量。

采用3,5-二硝基水杨酸比色法测定活性,在含有7 mmol/L海藻糖的25 mmol/L柠檬酸-磷酸钠溶液中,在30℃下测定酶活性,使产物的形成与样品蛋白浓度和测定时间(初速度)成正比。

包括不含酶或不含底物的对照。一个酶单位定义为每分钟水解1 μmol底物的量。
5、Rstre、Rstps1和Rstpp基因的克隆及表达构建
设计三对引物扩增这三个基因的转录本,PCR反应液中含有番茄红霉菌cDNA,每个引物0.25 μmol/L, dNTPs 200 μmol/L。

热循环包括在94℃下30秒,57℃下30秒和68℃下90秒的30个循环。
将得到的2.85 kb的Rstre、3.60 kb的和3.90 kb的片段克隆到克隆载体中。

用限制性内切酶和处理含有信号肽的克隆载体,将片段与含有湿霉素B耐药基因编码片段的载体混合,用T4 DNA连接酶连接。
编码整个转录本的表达质粒分别命名。

实验结果
1、Rstre、Rstps1和Rstpp基因的特征及表达模式
对海藻糖代谢相关基因进行了表征。编码序列长度分别为2 277、2 850和3924 bp。

预测的信号肽位于第18个氨基酸位点,中不存在信号肽。
使用2.0分析这些蛋白的跨膜结构域。结果显示,不存在跨膜结构域,而Rstps1中存在一个跨膜结构域。
结果显示,接种后3 ~ 5 d 基因表达量最高,而同一时期表达量最低。
这一阶段正好是菌核形成的时期,菌核形态在这一阶段发生了很大的变化。
因此,这一阶段的积累是最高的,海藻糖代谢相关的三个基因响应了菌核的发育。
接种后5 d, RSTPS1和RSTPP的表达水平显著下降,说明海藻糖代谢相关基因编码的蛋白响应了菌核的发育。
2、Rstre、Rstps1和Rstpp基因在毕赤酵母中的异源表达导致转化子酶活性发生显著变化
得到了三个变形子,用绝对定量法测定三个基因在不同转化体中的拷贝数。
将样品稀释至4个梯度,荧光定量得到的CT值重现性好。放大曲线和熔化曲线显示放大效率良好。
选择高拷贝转化子进行进一步研究,结果显示,这些蛋白在P,在转化菌发酵液的液相色谱标准曲线中,除了溶剂峰外,还可以清晰地看到另外三个峰。

通过标准峰及其保留时间对比,转化菌胞内可以通过催化麦牙糖产生海藻糖,酶活分别为3 124.7和3 318.3 U/mL。
GS115转化中的胞内RSTRE通过催化海藻糖产生葡萄糖,酶活性为3 672.3 U/mL。

3、Rstre、Rstps1和Rstpp基因在巴氏酵母中的异源表达影响转化子的含量
得到了三个变形子用绝对定量法测定三个基因在不同转化体中的拷贝数。
将样品稀释至4个梯度,荧光定量PCR得到的CT值重现性好,放大曲线和熔化曲线显示放大效率良好。

选择高拷贝转化子进行进一步研究,结果显示,这些蛋白在P。
在转化菌发酵液的液相色谱标准曲线中,除了溶剂峰外,还可以清晰地看到另外三个峰。

通过标准峰及其保留时间对比,转化菌胞内和可以通过催化麦牙糖产生海藻糖,酶活分别为3 124.7和3 318.3 U/mL。
转化中的胞内通过催化海藻糖产生葡萄糖,酶活性为3 672.3 U/mL。

4、转化菌发酵液对茄枯菌菌核数量有影响
采用荧光微孔板系统检测及其转化子的含量。
结果表明,发酵过程中活性氧含量显著降低转化体的发酵液中含量显著降低,在发酵液中添加海藻糖后ROS含量可以恢复。

然而,Rstre转化体中的ROS含量明显增加,并且在发酵液中添加海藻酶*制剂抑**——井冈霉素后,ROS含量可以恢复。
5、RSTPS1相互作用蛋白的分离
将3个转化体的发酵液添加到马铃薯葡萄糖琼脂(PDA)培养基中,制备含有的发酵液培养皿,用于培养RSB病原菌枯萎病菌。

结果表明,发酵液在每个PDA平板上的菌核干重均显著增加,而的菌核干重则明显减少,说明各处理菌核干重均与对照有显著差异。
这些发现表明,这些海藻糖代谢相关基因可以调节龙葵菌核的发育。

实验结果讨论
1、海葵海藻糖与菌核发育
本研究揭示了海藻糖代谢途径在茄茄菌核发育中的作用,根据我们之前的研究,茄茄的巩膜发育受ROS调控。
海藻糖是许多生物对环境胁迫的反应,也是一种有效的活性氧清除剂。

近年来,一些有关海藻糖代谢对真菌致病性和宿主-病原体相互作用影响的研究已经开展。
当各向异性绿僵菌的3基因被敲除时,基因缺失突变体不能很好地利用外源海藻糖作为唯一的碳源,表现出生长缓慢、毒力弱的特性。

另一个例子是,敲除白色念珠菌中的3基因可降低毒力。
因此,该基因可作为筛选新型抗真菌物质的潜在靶点。

黑曲霉的3个基因敲除突变体仅产生少量活性分生孢子,并且在分生孢子萌发过程中不能降解细胞内海藻糖。
2、Rstre、Rstps1和Rstpp可以通过诱导氧化应激调节硬化发育
在海藻糖分解途径中,TRE作为关键酶特异性直接将海藻糖分解为两个葡萄糖分子。

在海藻糖合成途径中,可以催化葡萄糖合成海藻糖。
TRE通过分解海藻糖来降低真菌细胞中海藻糖的含量,而较少的海藻糖不能有效去除过量的,必然导致真菌细胞中ROS的积累,过量会诱导真菌分化形成菌核。

3、与RSTPS1相互作用的ROS相关蛋白值得进一步研究
为了进一步的研究,我们的兴趣集中在与相互作用的蛋白质上。
通过技术,发现178个蛋白相互作用,其中16个蛋白相关。

这些研究结果将为开发高效的新型杀菌剂提供新的分子靶点,以控制,降低对环境的危害。
这些结果也证实海藻糖代谢相关基因可能通过调控中含量来诱导硬化发育。

这些相互作用的蛋白也可能影响茄茄菌核的发育,这样,我们可以获得更多有价值的分子靶点,用于开发高效的杀菌剂来防治病。
参考文献
[1]Bookout A L, Cummins C L, Mangelsdorf D J, Pesola J M, Kramer M F,
2006。高通量实时定量反转录PCR。现代生物医学杂志,15(8):15.8.1-15.8.21。
[2]范克强,金立强,郑永刚。2009。海藻糖酶的酶学性质及其作为新型农药靶点的开发。生物化学,26(4):7-11。
[3]方永忠,杨松,吴国勇。2002。自由基,抗氧化剂和营养。营养学报,18:872-879。
[4]Georgiou C D, Tairis N, Sotiropoulou A,2000。羟基自由基清除剂抑制菌核菌和枯核菌的菌核分化和生长。中国生物医学工程学报,32(4):391 - 396。
[5]Georgiou C D, Patsoukis N, Papapostolou I, Zervoudakis G,2006。丝状真菌的硬化变态是由氧化应激诱导的。生物工程学报,26(6):691-712。